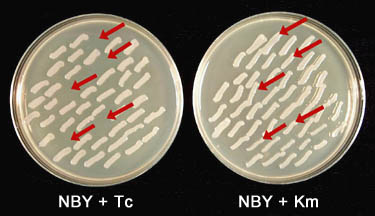

In order to resolve the function of a gene, it must be mutated or disrupted. This can be accomplished by transposon mutagenesis or site-directed insertional mutagenesis. Electroporation can then be used to introduce the mutated gene into the wild type organism by transformation. The mutated gene can then recombine into the genome via homologous recombination to disrupt the wild type gene.
The syrB gene from Pseudomonas syringae pv. syringae strain B301D was previously mutated by site-directed insertional mutagenesis. The syrB gene codes for a syringomycin synthetase and is partly responsible for the biosynthesis of syringomycin (13). In this exercise, the mutated syrB gene will be transformed into P. syringae pv. syringae strain B301D by electroporation. It is carried on the plasmid pBR325 which is not a broad host range plasmid and will not be maintained in P. syringae pv. syringae, promoting homologous recombination. Through the process of homologous recombination, the mutated gene should recombine into the genome disrupting the wild type syrB1 gene. The resulting mutants can then be evaluated for a change in phenotype. In this case, the loss of the ability to produce syringomycin can be determined using a syringomycin bioassay.
MATERIALS:
Media
CLICK HERE FOR MEDIA RECIPES:
Bacterial strain
P. syringae pv. syringae strain B301D
Plasmid DNA
Suicide plasmid DNA carrying a disrupted gene
Broad host range plasmid DNA (control)
-
pRK415, an RK2-derived broad host range vector 13 kb in size, Tcr (5).
-
pUCP26, a pUC-derived vector, 4.8 kb in size, carrying the 1.9-kb PstI fragment enabling the plasmid to be maintained in Pseudomonas, Tcr (13).
Equipment
-
Micropipetors (1000 µl, 250 µl, and 25 µl capacity)
-
Sterile pipet tips
-
Gene Pulser II electroporation system with Pulse Controller II Unit (Bio-Rad Laboratories, Hercules, CA)
-
cuvettes (0.1 cm) (store these at -20ºC and keep on ice until you are ready to use them)
CLICK HERE FOR Instructor's Note 1
-
Sterile glass test tubes.
-
Shaking incubator (25°C)
-
Glass hockey stick for spreading bacteria
-
Microfuge tubes (1.5 and 0.5 ml capacity)
-
Sterile distilled water
CLICK HERE FOR Instructor's Note 2
PROCEDURE:
1. Inoculate an NBY plate with freshly growing cells of P. syringae pv. syringae strain B301D (<24 h old) using a sterile loop, so that a lawn of bacteria will grow. Incubate the petri plate at 25°C overnight (~16 h). The bacteria should be in exponential to early stationary phase. Using bacterial cells in late stationary phase can reduce the efficiency of electroporation, therefore, cultures greater than 24-h old should not be used.
 |
| Figure 1. Bacterial lawn of P. syringae pv. syringae strain B301D. The NBY plate was inoculated with the bacterial strain B301D and incubated at 25ºC for ~ 16 h. |
2. Resuspend the bacterial lawn using 4 ml of cold sterile distilled water (SDW). Be careful not to resuspend small pieces of agar, because the presence of agar in the bacterial suspension will decrease the electroporation efficiency. It is important to keep the bacterial cells on ice throughout the procedure to increase the electroporation efficiency.
3. Transfer the suspension to 1.5 ml microfuge tubes and pellet the cells (14,000 rpm for 1 min).
4. Resuspend each microfuge tube of cells in 1 ml cold SDW and repeat step 3 twice. After the second wash, resuspend the cells in ~400 ml of cold SDW for each petri plate of cells and place the microfuge tube of cells on ice. Remove a 5 µl aliquot and determine the cell concentration by dilution plating.
CLICK HERE FOR Instructor's Note 3
5. Electroporator settings: resistance=200
, voltage=1.8 kV/cm.
6. Pipet 60 µl of bacterial cells into a 0.5 ml microfuge tube with 1-2 µg of suicide plasmid and mix gently.
7. Pipet bacterial cells and the DNA suspension into an electroporation cuvette and electroporate.
CLICK HERE FOR Instructor's Note 4
8. Dilute the electroporation mix with 1 ml of SOC and place it in a test tube with 4 ml of SOC. Incubate with shaking at 25°C for 4 h.
9. Remove 1 ml aliquots and pellet the entire 5 ml culture in 1.5 ml microfuge tubes (14,000 rpm for 1 min).
10. Resuspend the bacterial cells in 200 µl of NBY broth per microfuge tube. Transfer 100 µl aliquots onto NBY agar plus Km and spread evenly across the agar surface using a sterile glass hockey stick. Transfer 100 µl aliquots of the control electroporation onto NBY agar plus Tc and spread evenly across the agar surface using a sterile glass hockey stick. Incubate the petri plates at 25°C for 48 h.
11. Allow the rest of the electroporation mix to incubate with shaking at 25°C overnight.
12. Pellet the cells and resupend in ½ volume NBY broth. Transfer 100 µl aliquots onto NBY agar plus Km and spread evenly across the agar surface using a sterile glass hockey stick. Transfer 100 µl aliquots of the control electroporation onto NBY agar plus Tc and spread evenly across the agar surface using a sterile glass hockey stick. Incubate the petri plates at 25°C for 48 h.
13. Pick the colonies that grow after 48 h and streak them onto NBY agar plus appropriate selection to get single colonies. Incubate the plates at 25°C for 48 h. Note: Strains that only transiently carry the resistance (i.e., homologous recombination has not occurred) will not grow out to single colonies at this step.
14. Single colonies that grow and are Kmr should be tested for marker exchange (homologous recombination). Replica plate single colonies onto NBY agar plus Km and NBY agar plus Tc, for plus/minus screening.
|
| Figure 2. Plus/minus screen for marker exchange. All of the selected colonies will grow on NBY plus Km. The colonies in which marker exchange (i.e., homologous recombination) occurred will be sensitive to tetracycline and will not grow on NBY plus Tc. The kanamycin resistant and tetracycline sensitive colonies are selected for further analysis. |
15. Colonies that are Kmr and Tcr are potential strains in which homologous recombination occurred between the wild-type gene and the disrupted gene. These strains can be analyzed for an effect on syringomycin production using the toxin bioassay for syringomycin production.
 |
| Figure 3. Homologous recombination results in the replacement of the wild-type gene with a disrupted gene on the bacterial chromosome. This disrupted gene carries a gene conferring resistance to an antibiotic, in this case kanamycin, to the bacterial strain. |
CLICK HERE FOR Instructor's Note 5
CLICK HERE FOR Instructor's Note
6
16. The genomic DNA from colonies that are Kmr and Tcs can be isolated and analyzed using Southern hybridization to confirm absence of the suicide vector and the disrupted gene's location.
CLICK HERE FOR Instructor's Note 7
OBSERVATIONS:
1. Calculate the efficiency of marker exchange mutagenesis for the suicide plasmid. This is reported as transformants/µg DNA.
2. Calculate the electroporation efficiency for the control plasmid.
Efficiencies of transformation can vary but generally an electroporation efficiency for transformation of a broad host range plasmid into P. syringae pv. syringae strain B301D can range from 1 x 104 transformants/µg DNA to 1 x 105 transformants/µg DNA depending on the size of the plasmid. Efficiencies of marker exhange mutagenesis can range from 1 x 101 transformants/µg DNA to 1 x 104 transformants/µg DNA depending on how much homologous DNA is flanking the cassette insertion
QUESTIONS FOR DISCUSSION:
-
1. How do the marker exchange mutagenesis efficiency and the efficiency of electroporation for the broad host range plasmid compare?
-
2. Why is there such a difference between the efficiency of transformation and the efficiency for marker exchange mutagenesis?
CLICK HERE FOR Instructor's Note 8